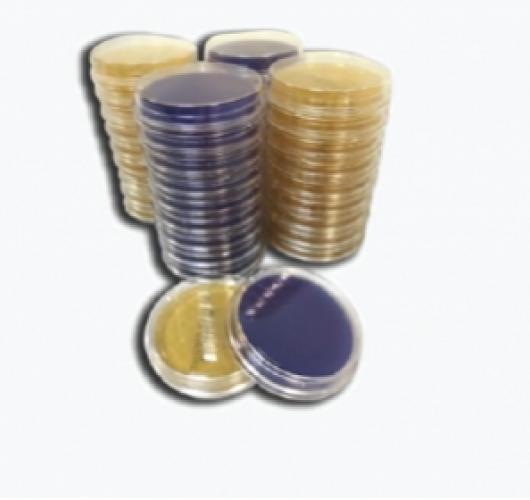
Контактная чашка Агар МакКонки(одинарный пакет)

Контактная чашка Агар МакКонки(одинарный пакет)
Информация
КОНТАКТНАЯ ЧАШКА АГАР МАККОНКИ - SURCHECK MAC CONKEY AGAR
Селективная среда, обеспечивающая превосходную дифференциацию между колиформными бактериями и бактериями, не ферментирующими лактозу, с подавлением роста грамположительных микрококков.
Категория:
Microorganism: Enterococcus faecalis, Eschrichia coli
Производитель:
Артикул: 06142
Кол-во: 10 шт.
Микроорганизм | Инокулят (КОЕ) | Результаты | ||
Рост | Реакция | |||
| Escherichia coli ATCC 25922 | 10-100 | Хороший | Хорошая.Красные колонии | |
Shigella sonnei ATCC 25931 |
| Хороший | Хорошая.Соломенно-желтые колонии | |
| Enterococcus faecalis ATCC 29212 | 100-1000 | Подавленный | Подавленный. | |
Tемпература хранения: 2-12°С
Срок хранения: 4 месяцев
Микробиологический контроль: инкубировать в течение 24 часа при 35 ° С
Упаковка содержит 10 штук контактных чашек